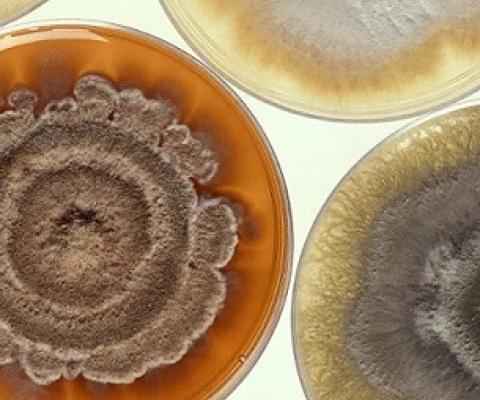
Scientists Find Bacteria so Alien to Human Immune System It Can’t Detect It. Credit - CC0

More News & Sources of Information
The following are excellent sources for the latest news, literature, webinars, videos and audio on marine protected areas, marine pollution, marine management, ocean and marine planning, ecosystem-based management, grants, jobs, and much more. Click each icon to learn more and to subscribe.
Image

Image